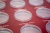
00021641_5

Капсульный альбом на кольцах "Биметаллические монеты России 10 рублей" без разделения на мон. дворы
Артикул:
00021641
Капсульный альбом на кольцах "Биметаллические монеты России 10 рублей" без разделения на мон. дворы
Подробнее
Нет в наличии
Подписаться
Описание
Капсульный альбом на кольцах — это тематическая папка с кольцами, в которую вставлены “капсульные” листы.
“Капсульные” листы — условное название. В таких листах каждая монета крепко держится в своей ячейке и не крутится. Ячейки закрываются плотным пластиком, но не герметично.
Монету в “капсульном” листе видно с двух сторон.
В альбоме подписаны ячейки для биметаллических монет России номиналом 10 рублей с 2000 по 2019 год. В альбоме не учитывается разделение на монетные дворы.
Серия не закончена, альбом будет меняться. Со временем выйдет дополнительный лист с подписанными ячейками.
Всего в альбоме 6 листов. Есть 19 ячеек без подписей.
Внешний размер альбома:
Высота — 240 мм
Ширина — 203 мм
Характеристики
|
Страна
|
Россия |
|
Высота и ширина
|
240 х 203 мм |
Задать вопрос